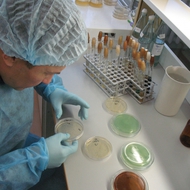

Паразитология
Для специалистов с высшим медицинским образованием
Часы: 144 ч. (1 мес.)

Безопасность работы с микроорганизмами III-IV группами патогенности и возбудителями паразитарных заболеваний
Краткосрочные курсы
Часы: 72 часа

Актуальные вопросы скорой медицинской помощи
Курсы в системе НМО
Часы: 36 часов


Патологическая анатомия
Для специалистов с высшим медицинским образованием
Часы: 144 ч./576ч.

Искусственная вентиляция легких у пациентов с коронавирусной инфекцией COVID-19
Курсы в системе НМО
Часы: 36 часов

Педиатрия
Для специалистов с высшим медицинским образованием
Часы: 144 ч./576 ч.


Актуальные вопросы профилактики неинфекционных заболеваний и проведения мероприятий по формированию здорового образа жизни в медицинских организациях
Краткосрочные курсы
Часы: 36 часов